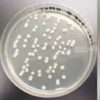

OVERVIEW NANOTECHNOLOGY
As the threat of biological warfare grows, countermeasures are needed to defend against it. We has provided the U.S. military, first responder, and emergency health professionals the tools to effectively detect biothreat. We take pride in producing the world’s best rapid assays and handheld assays for the detection of biological warfare agents in white powder.
Not only can our multiplexed assays detect up to 5 targets at a time in a single ticket, but they are also immune to the high-dose Hook effect, a highly dangerous false negative result in the presence of high concentration of biothreat agents.
Nano Intelligent Detection System

We create’s produces the world’s best rapid assays or handheld assays (HHAs) for the detection of biological warfare agents in white powders. By using its proprietary nanomanipulation technology, multiplexed assays can detect up to 5 targets at one time using one test ticket, with improved sensitivities over commercially available single-target HHAs.
Pathogen and Biological Toxins
-
One test for multiple targets – Multiplex
-
No false negatives caused by the Hook effect
-
High specificity against near neighbor, suspicious powders, and CRP Interference Panels
-
Multiple third party evaluations confirm efficacy with live agents and absence of high‐dose hook effect.
- Ordering Details
- Single target assay to detect generic E-coli
- Single target assay to detect 6 E. coli 0157
- Single target assay to detect Salmonella
- Singlae target assay to detect Listeria
- Single target assay to detect Botulinum Toxin A and B
- Single target assay yo detect Satphylococcal Enterotoxin B (SEB)
- Single target assay to detect Ricin
- Single target assay to detect Vibrio cholerae
- SAR IV Reader with BW 1-Plex firmware
The Hook Effect
rapid tests do not suffer from the high-dose hook effect
Effect on Handheld Assays

The high-dose hook effect causes a false negative result when large amounts of a threat agent present in a test sample oversaturate the test reagents, disabling their ability to generate a positive signal. Other rapid assays overcome this by running several dilutions of an unknown sample on multiple tests, which significantly increases cost and operational complexity. The tests avoid this wasteful practice entirely.

The Hook Effect in traditional lateral flow assays is a false negative result in the presence of high concentrations of biological agents.
The sensitivity, specificity, and accuracy of The rapid tests along with a handheld reader for biological warfare agents have been verified independently by third party laboratories. Our tests have proven robust in the presence of a large variety of interferences.The handheld stand alone reader (SAR), capable of analyzing and storing over 5,000 test results, completely eliminates human to human reading variations of hand held assays, particular under low lighting conditions. Our multiplexes and reader are currently in use by various units of the US armed forces and by the Department of Homeland Security.